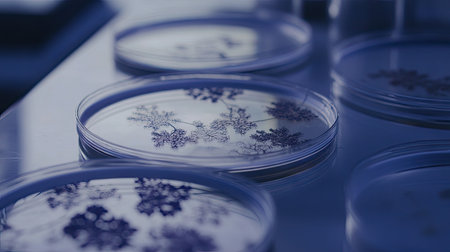
Multiple Petri dishes with various microorganism cultures on a clean lab table, each dish showing unique bacterial patterns.の素材

素材 - Multiple Petri dishes with various microorganism cultures on a clean lab table, each dish showing unique bacterial patterns.
作品情報
Multiple Petri dishes with various microorganism cultures on a clean lab table, each dish showing unique bacterial patterns.
- ID:259917023
- 作品種別:
- 作者名:suphauarrn Manosri
キーワード
- acid
- algae
- aromatherapy
- backgrounds
- bacterial
- beauty
- beige
- biology
- body care
- care
- cellular
- clean
- colony
- color image
- condition
- crisp
- culture
- detail
- detox
- discovery
- dish
- diversity
- drop
- ecology
- environment
- exam
- experiment
- green color
- healthy lifestyle
- horizontal
- investigation
- laboratory
- lifestyles
- liquid
- microscopic
- moisturizer
- multiple
- nature
- no people
- observation
- organic
- pink color
- refreshment
- sample
- science
- scientific
- specimen
- study
類似作品
microbial cultu...
Mold and other ...
Generative AI
Microbiology La...
array of petri ...
petri dishes wi...
petri laborator...
A vibrant mosai...
Colorful, iride...
Petri dishes co...
microbial cultu...
This image show...
Alternative nat...
Cosmetic swatch...
heritage seeds ...
Colorful, iride...
Different types...
Growth of diffe...
Petri dish with...
Multiple Petri ...
Background with...
close-up of pet...
Petri dish with...
Test tubes with...
Petri dishes wi...
A cluster of va...
A top-down view...
microbial cultu...
A group of petr...
Different color...
Top view of cos...
A stunning arra...
Colorful petri ...
Plastic Plates ...
Petri dishes wi...
microbial cultu...
A glass pipette...
Microbiology la...
Test tubes with...
culture petri d...
A diverse array...
Microbiology La...
Soft pastel bok...
A visually stri...
close-up of pet...
Mold and other ...
A close-up of p...
Viruses and bac...
laboratory bact...